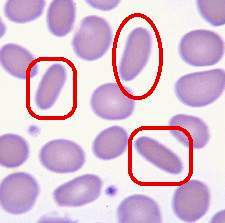
遗传性椭圆形红细胞增多症
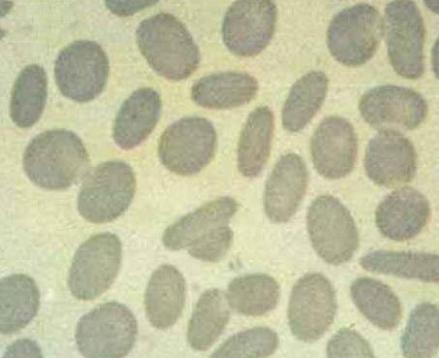
遗传性椭圆形红细胞增多症
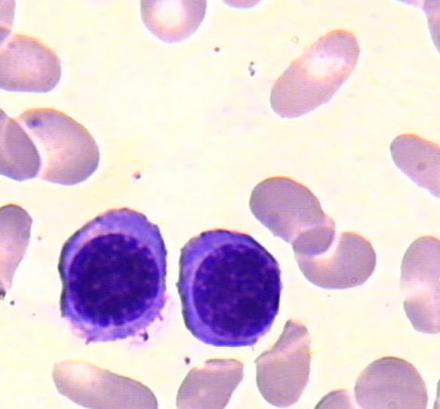
遗传性椭圆形红细胞增多症
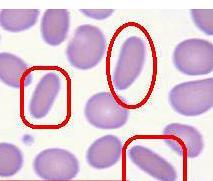
遗传性椭圆形红细胞增多症
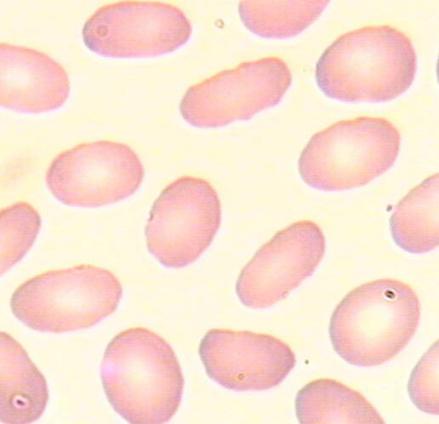
遗传性椭圆形红细胞增多症
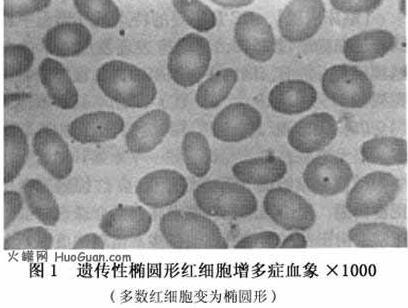
遗传性椭圆形红细胞增多症
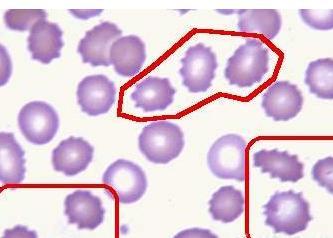
遗传性椭圆形红细胞增多症

-
遗传性椭圆形红细胞增多症 编辑
遗传性椭圆形红细胞增多症(hereditary elliptocytosis ,HE)是一组异质性家族遗传性溶血性疾病,特点是外周血中存在大量的椭圆形成熟红细胞。HE首先由Dresbach于1904年报道,同年,Hunter描述了HE的临床特征并确定它为一种遗传病。经过近100年的研究,认为HE是一组由于红细胞膜蛋白分子异常而引起的遗传性溶血病。
中医病名:遗传性椭圆形红细胞增多症
外文名:hereditary elliptocytosis
类别:异质性家族遗传性溶血性疾病
遗传性椭圆形红细胞增多症
遗传性椭圆形红细胞增多症
2轻度溶血(溶血代偿型):红细胞寿命比正常稍短,网织红细胞轻度增高,结合珠蛋白低于正常,由于造血功能的代偿,多不出现贫血。绝大多数病人属于这一类型。严重的可在新生儿期出现高胆红素血症,甚至需要换血治疗。合并感染时可出现骨髓不增生危象,亦有合并胆石症的报道。
遗传性椭圆形细胞增多症是一种以外周血液中椭圆形细胞增多至25%以上为特点的遗传性疾病。正常人的外周血液中亦可有少数椭圆形红细胞,但至多不超过15%,而遗传性椭圆形细胞增多症患者中这种细胞至少有25%,更多见的是超过75%,甚至多达90%。椭圆形红细胞的横径和纵径的比率不超过0.78。遗传性椭圆形细胞增多症患者不全都有溶血现象,临床上发生溶血性贫血者仅占10%~15%左右。遗传性椭圆形细胞增多症在世界各民族中均有发现。我国亦有少数病例报道。本病为遗传性疾病,由常染色体显性传递。男女均可得病。各家族间溶血的程度很不一致。在部分患者中,本病的基因与rh血型的基因位于同一染色体上。两种基因不联接时,则溶血较严重。
 遗传性椭圆形红细胞增多症
遗传性椭圆形红细胞增多症
本病与遗传性球形细胞增多症有相似之处,如细胞形态异常者在脾脏内破坏增多,胞膜中存在着某种通透性方面的缺陷促使三磷酸腺苷的利用加速。但致使红细胞变成椭圆形的原因究竟是什么,还有待科学家的进一步探讨。
 遗传性椭圆形红细胞增多症
遗传性椭圆形红细胞增多症
遗传性椭圆形红细胞增多症
遗传性椭圆形红细胞增多症
遗传性椭圆形红细胞增多症
遗传性椭圆形红细胞增多症
3.除一般溶血性贫血化验所见;可见血片中有球形或椭圆形红细胞,数量可从1-2%到60-70%,多数在10%以上(正常人一般低于5%);
4.红细胞渗透脆性增高;
5.酸化甘油溶解试验阳性;
6.SDS-聚丙烯山胺凝胶电泳进行红细胞膜蛋白分析,部分病例可发现膜骨架蛋白缺陷。
遗传性椭圆形红细胞增多症
遗传性椭圆形红细胞增多症
遗传性椭圆形红细胞增多症
遗传性椭圆形红细胞增多症
遗传性椭圆形红细胞增多症
遗传性椭圆形红细胞增多症
遗传性椭圆形红细胞增多症
遗传性椭圆形红细胞增多症
3.对长期使用激素者,应预防性使用抗生素。
4.按普外科腹部手术前准备。
.手术可取左侧肋缘下或上腹正中“L”形切口,术野显露充分。2.切睥前宜先结扎脾动脉。
 遗传性椭圆形红细胞增多症
遗传性椭圆形红细胞增多症
4.血液病患者须将副脾一并切除。
5.切除脾脏时注意不要损伤胰尾部,以免术后发生胰瘘。
1.按一般腹部手术后处理。2.引流管一般于术后24~48h拔除。
3.术后每日查白细胞和血小板。术后当血小板超过(0.8~1)×1012/L时,应行抗凝治疗。
 遗传性椭圆形红细胞增多症
遗传性椭圆形红细胞增多症
3.无效:脾切除后症状及血象均无改善;
4.复发:脾切除后有效,以后再次恶化。
本病系遗传性疾病,无特殊根治疗法。脾切除可减低脾脏对周围血中异形红细胞的清除作用。对术后效果不能期望太高,术前应向病人及其家庭交代清楚。另嘱病人平时注意避免劳累和感染,以免引起急性溶血发作。
1.红细胞形态外周血中椭圆形、卵圆形雪茄形或腊肠形成熟红细胞增多。此种形态异常,在出生时可能不存在多于生后4~6个月开始出现。另外,在球形细胞性HE,尚有小球形红细胞和小椭圆形细胞;在口形细胞性HE,有许多细胞膜僵硬的口形细胞细胞中央浅染区有棒状结构将其分割。溶血严重时周围血象中可出现球形细胞或红细胞碎片网织红细胞和有核红细胞形态正常。2.红细胞脆性试验普通型HE大多正常在球形细胞性HE和重型HE患儿则增高。孵育后的脆性试验和自溶试验轻度增高,加葡萄糖或ATP后可被纠正。
3.红细胞自溶试验在球形细胞性HE增高,加入葡萄糖或ATP仅部分纠正。各类型HE的红细胞变形性均减低。51Cr标记红细胞显示寿命明显缩短,多在脾脏内破坏。在HPP红细胞对热敏感(45~46℃即破碎正常红细胞要49℃才破碎)。
患儿,男,7岁。因脸色苍白4年,加剧4个月,于1997年4月8日入院。发病时无发热及全身性出血倾向。既往体健,否认苯等化学物质及放射性核素接触史,无服用细胞毒性药物及氯霉素、磺胺药、解热镇痛药史。5个月前在当地查Hb70g/L,经抗贫血治疗无明显效果。查体:面色苍白,全身浅表淋巴结未触及,皮肤、巩膜无黄染及瘀点、瘀斑,心率80次/分,无病理性杂音,腹平软,肝、脾肋缘下未扪及,神经系统未发现异常。实验室检查:Hb50g/L,WBC2.9×109/L,BPC47×109/L,Ret0.005,多数成熟红细胞呈椭圆形;尿胆红素(-),尿胆原4.2μmol/L,天冬氨酸转氨酶48IU/L(速率法);B超:肝正常,脾厚2.5cm,肋缘下0.5cm;骨髓象:增生减低,粒系占0.220,红系占0.035,粒∶红=6.3∶1,粒细胞形态未见明显改变,大多数成熟红细胞呈椭圆形,占0.780,淋巴细胞比例增高,以成熟淋巴细胞为主,形态大致正常,巨核细胞全片1个,血小板少见;细胞外铁(+);骨髓小粒以非造血细胞为主;红细胞脆性试验、血红蛋白电泳均未见异常。诊断:遗传性椭圆形红细胞增多症,再生障碍性贫血。其母外周血大多数红细胞呈椭圆形;其父外周血成熟红细胞形态大致正常。入院后给予康力龙、利血生、硝酸一叶秋碱、皮质激素、胸腺肽等治疗,外周血象改善,住院27天出院。出院时检查WBC8.9×109/L,Hb70g/L,BPC49×109/L,Ret0.009。
1、本站所有文本、信息、视频文件等,仅代表本站观点或作者本人观点,请网友谨慎参考使用。
2、本站信息均为作者提供和网友推荐收集整理而来,仅供学习和研究使用。
3、对任何由于使用本站内容而引起的诉讼、纠纷,本站不承担任何责任。
4、如有侵犯你版权的,请来信(邮箱:baike52199@gmail.com)指出,核实后,本站将立即删除。
下一篇 脾功能亢进
上一篇 遗传性球形红细胞增多症






























